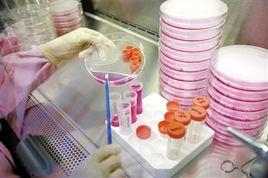
細胞復甦 細胞復甦

介紹
1. 從液氮容器中取出凍存管,直接浸入37℃溫水中,並不時搖動令其儘快融化。2. 從37℃水浴中取出凍存管,打開蓋子,用吸管吸出細胞懸液,加到離心管並滴加10倍以上培養液,混勻;3. 離心, 1000rpm,5min;4. 棄去上清液,加入含10%小牛血清培養液重懸細胞,計數,調整細胞密度,接種培養瓶,37℃培養箱靜置培養;5. 次日更換一次培養液,繼續培養。
細胞復甦細胞復甦是與細胞凍存相反的過程,即是細胞恢復生長的過程,是將凍存在液氮或者-70℃冰櫃中的細胞解凍之後重新培養。當恢復到常溫狀態時,細胞的形態結構保持正常,生化反應即可恢復。與細胞凍存不同,細胞復甦過程升溫要快,防止在解凍過程中水分進入細胞,形成冰晶,影響細胞存活。
主要步驟
①將冷凍管從液氮中取出,迅速投入37℃水浴融化,細胞融化後要儘快(約1min)移出37℃水浴。37℃水浴時間延長會提高細胞死亡率,復甦過程中一般細胞死亡率在20%~25%之間。
②迅速用酒精棉球擦拭冷凍管外部殺菌消毒,然後放置在冰浴上。
③小心開啟瓶蓋,把細胞轉入含有4mL培養基的培養瓶中,然後把培養瓶移至培養箱,26℃~28℃培養1h,讓細胞貼壁。
④細胞貼壁後,小心移棄培養基,主要是去掉DMSO(懸浮生長細胞要通過離心沉澱除去DMSO)、死細胞及其碎片,加5mL新鮮培養基,26℃~28℃培養。
⑤細胞培養24h後,更換新鮮培養基,繼續培養直到形成單層,便可以傳代。
⑥詳細記錄復甦細胞的名稱、數量、復甦時間、存放部位等。
結果分析
判斷細胞復甦成功與否,需要看復甦後細胞貼壁率及細胞存活率(細胞存活率將凍存管內剩餘的細胞,用台盼藍染色法檢測復甦細胞的存活率。呈藍色的細胞為死細胞,活細胞不著色。用細胞計數板和計數器計數細胞,得出細胞存活率)。如果復甦後95%以上的細胞貼壁,而且細胞的活性好,這就說明細胞復甦的過程沒有問題。復甦的細胞恢復到正常生長,達到正常的生長特性(比如細胞群體倍增時間等)後要再凍存以補充細胞儲存數量。
注意事項
1、注意無菌操作。
2、應在1-2min內使凍存液完全融化。如果復溫速度太慢,則會造成細胞損傷。另外,細胞復甦後的操作最好在4℃冰浴中進行,以減少冷凍保護劑對細胞的毒性。
3、細胞復甦過程中,升溫的速率要大,把從液氮或-70℃冰櫃中取出的細胞在最短的時間內放入水浴鍋。
4、細胞放入水浴中注意用鑷子夾住細胞凍存管並在水浴中不時晃動,使其受熱均勻,並防止水浴時水進入細胞凍存管污染細胞。打開細胞凍存管之前要用酒精棉球將凍存管消毒並晾乾。
5、液氮操作有一定的危險性,打開液氮罐取出細胞時,戴上防護眼鏡。
6、如果凍存管密封不嚴,液氮可被吸入。由於解凍時凍存管中的氣溫急劇上升,將可能發生爆炸。復甦過程中應蓋上恆溫水浴鍋的蓋